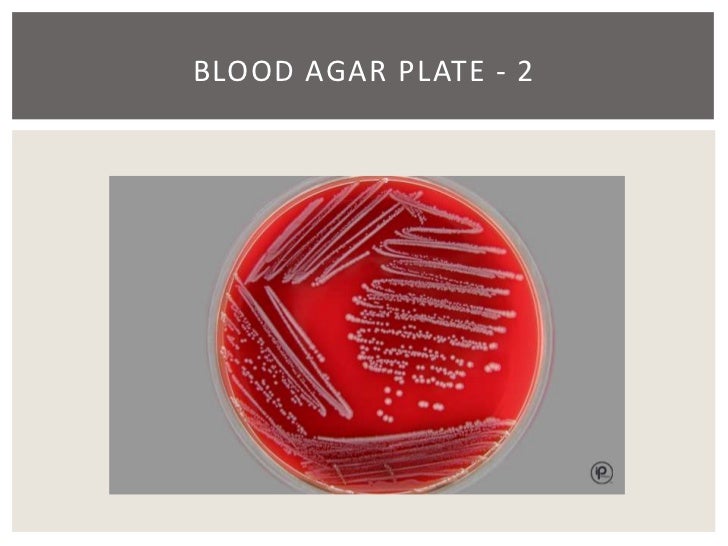
24 hours test blood 16 enterobacteriaceae chapter  19

16 BLOOD TEST 24 HOURS
BLOOD TEST 24 HOURS
Hai, thank you for visiting this url to search for blood test 24 hours. I am hoping the information that appears can be helpful to you









Blood Products and Services Red Cross Blood Services , Blood components and preparation , Best Blood Stock Photos, Pictures & Royalty Free Images , About our Clinic , 16 chapter 19 enterobacteriaceae , Life , LECTURES/EXAMINATION , Invalid Consent Leads To Exclusion Of Blood Test Dayton , Lyme Disease in Dogs: Symptoms, Testing, Treatment, and , jm's Adventure with Multiple Myeloma: 2nd ASCT Day 55 , Roadside drug tests Cannabis, meth, ice, detection times , Barium enema Health Navigator NZ , High Desert Equine Horse Health Articles Late , Method of quantitative bacterial count ,
Hai, thank you for visiting this url to search for blood test 24 hours. I am hoping the information that appears can be helpful to you

Belum ada Komentar untuk "16 BLOOD TEST 24 HOURS"
Posting Komentar